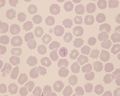
Babesia canis hund 010 klein.jpg
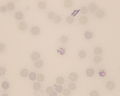
Retikulozyten 019.jpg

Nicht kategorisierte Dateien
Unten werden bis zu 14 Ergebnisse im Bereich 1 bis 14 angezeigt.
Zeige (vorherige 50 | nächste 50) (20 | 50 | 100 | 250 | 500)
- 027Mikrofilarie Labopedia.jpg027Mikrofilarie Labopedia.jpg Datei fehlt
- 027 Mikrofilarie.svg027 Mikrofilarie.svg Datei fehlt
- Aelurostrongylus abstrusus klein.jpg 750 × 563; 93 KB
- Anaplasma phagozytophil hund 005 klein.jpg 750 × 600; 23 KB
- Babesia canis hund 010 klein.jpg 750 × 600; 28 KB
- DipylidiumEipaket klein.jpg 750 × 500; 26 KB
- Haemobartonella felis Katze 012 klein.jpg 750 × 600; 19 KB
- Hund-hapatozoon-canis2 klein.jpg 750 × 600; 33 KB
- Hund Hautabklatsch leishmaniose 016 klein.jpg 750 × 600; 34 KB
- Leguan-mikrofilarien klein.jpg 750 × 600; 83 KB
- Leishmanien Hund 014.jpg 1.280 × 1.024; 454 KB
- Lungenwurmlarve-Reh.jpgLungenwurmlarve-Reh.jpg Datei fehlt
- Retikulozyten 019.jpg 1.280 × 1.024; 387 KB
- Sarcoptes canis.gif 400 × 265; 97 KB
Zeige (vorherige 50 | nächste 50) (20 | 50 | 100 | 250 | 500)